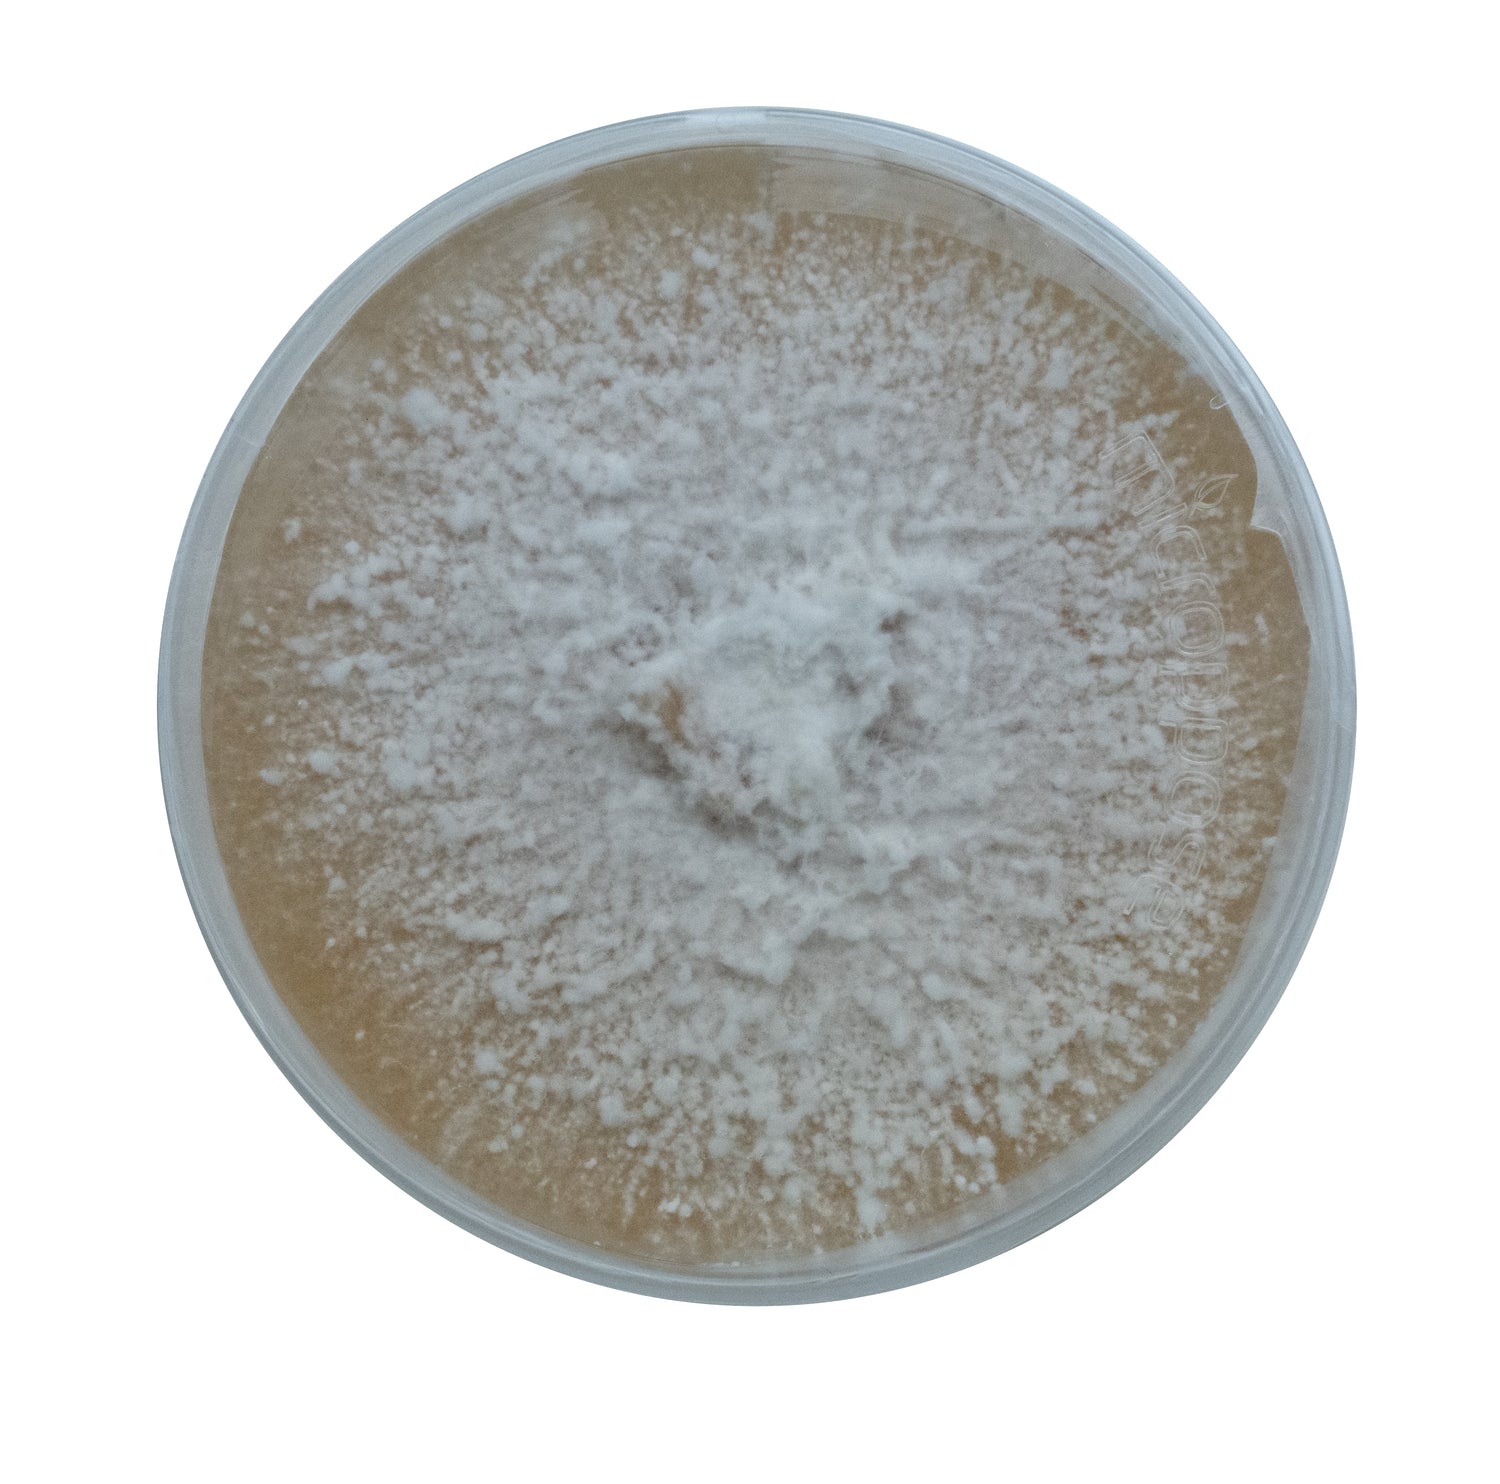

Get Your Very Own Fenrir Bagging System Today!
Shop nowSUBSCRIBE TO OUR EMAIL LIST
Be the first to know about new products and exclusive offers.
Our Commercial Products:
-

Agar Cultures
Orders placed within a given workweek (our business hours are Monday-Friday, 8...
-

Grain Spawn
Orders placed within a given workweek (our business hours are Monday-Friday, 8...
-

Ready to Fruit Substrate
Orders placed within a given workweek (our business hours are Monday-Friday, 8...
Bestsellers
-
G2 Grain Spawn (CERTIFIED ORGANIC)
Regular price $24.00 USDRegular priceUnit price / per -
Aerated Liquid Culture
Regular price $25.00 USDRegular priceUnit price / per -
Blue Oyster Ready to Fruit Substrate
Regular price $30.00 USDRegular priceUnit price / per -
Culture The SUN
Regular price $25.00 USDRegular priceUnit price / per
1
/
of
4

SO MANY STRAINS TO CHOOSE FROM

Learn about our spawn & cultures

Sign up with Mycowizards to watch a full length tour of our warehouse!

Check out the Mycowizards Podcast!
Founder of the company Erik Lomen talks fungi knowledge with head of R&D at Cap N' Stem, owners of other mushroom farms, and other unique figures in the mushroom community.

Subscribe to Mycowizards and Watch Our Brand New Video!
Check Out Our Youtube